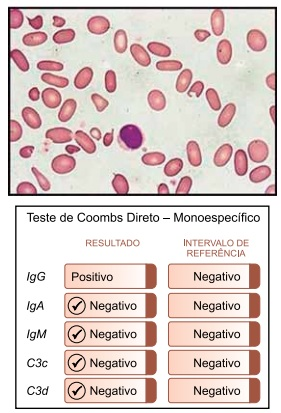
Enunciado 4449122-1

Foram encontradas 1.287 questões.
Paciente masculino, 52 anos, hipertenso e tabagista, deu entrada em um Pronto-Socorro Hospitalar, na
região leste de São Paulo, com dificuldade de respirar
e muito cansaço. Relatou que foi tratado há 20 dias de
uma pneumonia e que fez corticoterapia de 07 dias.
Todavia, não apresentando melhoras, este retornou à
unidade.
Foi solicitada uma tomografia, que demonstrou opacidades em vidro despolido com predomínio nas bases e periferia do parênquima pulmonar. Os exames laboratoriais não acusaram patógeno viral ou bacteriano, e o paciente foi submetido a um exame de biópsia pulmonar. A amostra cirúrgica foi recebida previamente fixada em formol tamponado a 4% e submetida ao processamento da análise com inclusão total do material. As secções obtidas foram coradas utilizando hematoxilina e eosina.
 Legenda: Espessamento de septos com infiltrado inflamatório.
Legenda: Espessamento de septos com infiltrado inflamatório.
 Legenda: Macrófagos com ferro.
Legenda: Macrófagos com ferro.
(Laboratório de Anatomia Patológica do Centro Universitário FMABC. Imagem usada com autorização)
O diagnóstico de DIP (pneumonia intersticial descamativa) foi feito correspondendo à clínica de pulmão do tabaco. O parênquima pulmonar demonstra presença de macrófagos intra-alveolares, multinucleados e com pigmento granular castanho contendo ferro, que é demonstrado pela técnica
Foi solicitada uma tomografia, que demonstrou opacidades em vidro despolido com predomínio nas bases e periferia do parênquima pulmonar. Os exames laboratoriais não acusaram patógeno viral ou bacteriano, e o paciente foi submetido a um exame de biópsia pulmonar. A amostra cirúrgica foi recebida previamente fixada em formol tamponado a 4% e submetida ao processamento da análise com inclusão total do material. As secções obtidas foram coradas utilizando hematoxilina e eosina.
 Legenda: Espessamento de septos com infiltrado inflamatório.
Legenda: Espessamento de septos com infiltrado inflamatório.
 Legenda: Macrófagos com ferro.
Legenda: Macrófagos com ferro. (Laboratório de Anatomia Patológica do Centro Universitário FMABC. Imagem usada com autorização)
O diagnóstico de DIP (pneumonia intersticial descamativa) foi feito correspondendo à clínica de pulmão do tabaco. O parênquima pulmonar demonstra presença de macrófagos intra-alveolares, multinucleados e com pigmento granular castanho contendo ferro, que é demonstrado pela técnica
Provas
Questão presente nas seguintes provas
A incidência global de amiloidose é estimada em cerca
de cinco a nove casos por milhão de pacientes/ano.
Os estímulos inflamatórios na amiloidose AA (amiloide
secundária ou reativa) estão associados à artrite inflamatória crônica (artrite reumatoide, espondilite anquilosante), doença inflamatória intestinal, infecções crônicas, síndromes de febre periódica hereditárias familiares
como a febre familiar do Mediterrâneo (FFM), neoplasias
e causas idiopáticas. O comprometimento renal é uma
manifestação comum na maior parte dos tipos de amiloidose sistêmica. Em biópsias, são feitas microscopia de
luz e imunofluorescência indireta (IF).
A figura a seguir demonstra a Micrografia de luz (LM) de um rim de paciente masculino, 58 anos mostrando depósitos de amiloide (laranja) nos glomérulos.

(Laboratório de Anatomia Patológica do Centro Universitário FMABC. Imagem usada com autorização)
Qual é o corante utilizado para detectar depósitos de amiloide em tecidos e as proteínas detectadas na IFI?
A figura a seguir demonstra a Micrografia de luz (LM) de um rim de paciente masculino, 58 anos mostrando depósitos de amiloide (laranja) nos glomérulos.

(Laboratório de Anatomia Patológica do Centro Universitário FMABC. Imagem usada com autorização)
Qual é o corante utilizado para detectar depósitos de amiloide em tecidos e as proteínas detectadas na IFI?
Provas
Questão presente nas seguintes provas
Para garantir um laudo fidedigno na avaliação do resultado de hemocultura venosa, é fundamental que a fase
pré-analítica seja rigorosamente controlada.
Nesse contexto, é correto, na coleta de hemoculturas,
Nesse contexto, é correto, na coleta de hemoculturas,
Provas
Questão presente nas seguintes provas
O diagnóstico clínico de glomerulopatias é sindrômico
e depende da dosagem laboratorial de biomarcadores.
Numerosas pesquisas estão sendo conduzidas para
fundamentar a relevância da utilização de biomarcadores no diagnóstico e monitoramento dessas condições.
Dessa forma, o biomarcador sensível que serve para
demonstrar a presença de glomerulopatia e início da
lesão renal é:
Provas
Questão presente nas seguintes provas
Paciente feminina, 42 anos, em tratamento dermatológico há 06 meses devido a uma dermatite no couro
cabeludo, sendo tratada com o princípio ativo do grupo
das sulfonas. A paciente em suas duas últimas consultas
comunicou sintomas como taquicardia, pressão baixa,
fraqueza e dores ósseas. Nos últimos dois hemogramas
realizados com intervalos de 20 dias, foram notadas
quedas da concentração do número de eritrócitos, do
hematócrito e presença de plaquetopenia. Ao diagnóstico de imagem na tomografia, foi relatado discreto
aumento do volume hepático.
Seguem a lâmina do sangue periférico e o resultado do teste de Coombs direto:

(LABFMABC do Centro Universitário FMABC. Imagem usada com autorização)
Com base nos resultados laboratoriais, é correto afirmar que
Seguem a lâmina do sangue periférico e o resultado do teste de Coombs direto:
(LABFMABC do Centro Universitário FMABC. Imagem usada com autorização)
Com base nos resultados laboratoriais, é correto afirmar que
Provas
Questão presente nas seguintes provas
A mucormicose, frequentemente referida como “fungo
negro”, é uma infecção fúngica grave causada por
fungos do grupo mucorales. Durante a pandemia de
Covid-19, houve um aumento significativo nos casos
de mucormicose, especialmente em pacientes que
apresentavam formas graves da doença ou que estavam em tratamento com corticosteroides, que podem
suprimir o sistema imunológico.
Qual dos seguintes exames laboratoriais é mais comumente utilizado para o diagnóstico de mucormicose?
Qual dos seguintes exames laboratoriais é mais comumente utilizado para o diagnóstico de mucormicose?
Provas
Questão presente nas seguintes provas
O uso do sequenciamento do exoma no prognóstico do
câncer de mama permite identificar mutações específicas
que podem estar associadas ao desenvolvimento e à progressão da doença. Essas informações podem ajudar os
médicos a determinar o risco de recorrência do câncer, a
eficácia de tratamentos e a personalização das terapias.
Além disso, o estudo do exoma pode revelar novos alvos
terapêuticos e contribuir para a pesquisa de novas abordagens no tratamento do câncer de mama.
É correto afirmar que o exoma
É correto afirmar que o exoma
Provas
Questão presente nas seguintes provas
No mecanismo hemostático, as plaquetas participam tanto
na hemostasia primária quanto na hemostasia secundária.
Qual método é considerado o padrão-ouro para a avaliação
da função das plaquetas?
Provas
Questão presente nas seguintes provas
Assinale a alternativa que melhor define o que é biópsia
líquida.
Provas
Questão presente nas seguintes provas
A síndrome de POEMS é uma condição rara que combina várias manifestações clínicas e é caracterizada
por cinco componentes principais, que dão origem ao
acrônimo “POEMS”: P – Polineuropatia; O – Organomegalia; E – Endocrinopatia; M – Monoclonalidade; S – Skin.
O tratamento pode incluir quimioterapia, radioterapia ou terapias direcionadas, dependendo da gravidade e da apresentação clínica.
Qual dos seguintes exames laboratoriais é mais relevante para o diagnóstico da síndrome de POEMS?
O tratamento pode incluir quimioterapia, radioterapia ou terapias direcionadas, dependendo da gravidade e da apresentação clínica.
Qual dos seguintes exames laboratoriais é mais relevante para o diagnóstico da síndrome de POEMS?
Provas
Questão presente nas seguintes provas
Cadernos
Caderno Container